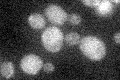
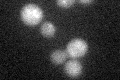
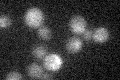

View description
Helicase encoded by the Y' element of subtelomeric regions, highly expressed in the mutants lacking the telomerase component TLC1; potentially phosphorylated by Cdc28p
Localization:
Intensity:
Fold change:
Significance:
-
C’ GFP library in SD
below threshold17 -
N' NOP1pr-GFP in SD

N/A0 -
N' TEF2pr-mCherry in SD

N/A0 -
N' NATIVEpr-GFP in SD

N/A0 -
N' TEF2pr-VC and Cyto-VN in SD

N/A0 -
C’ GFP library in SD+DTT
cytosol15.720.92No -
C’ GFP library in SD+H2O2

cytosol17.511.02No -
C’ GFP library in Starvation Media
cytosol16.140.94No -
C’ GFP library on the background of Pup2-DaMP

below threshold -
C’ GFP library on the background of CCT mutant

below threshold22.00271.29384No
